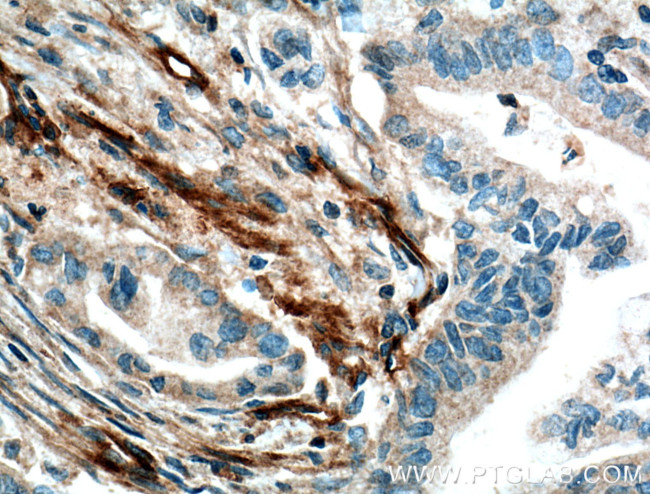
VWA1 Antibody in Immunohistochemistry (Paraffin) (IHC (P))

Search
Proteintech
VWA1 Polyclonal Antibody
{{$productOrderCtrl.translations['antibody.pdp.commerceCard.promotion.promotions']}}
{{$productOrderCtrl.translations['antibody.pdp.commerceCard.promotion.viewpromo']}}
{{$productOrderCtrl.translations['antibody.pdp.commerceCard.promotion.promocode']}}: {{promo.promoCode}} {{promo.promoTitle}} {{promo.promoDescription}}. {{$productOrderCtrl.translations['antibody.pdp.commerceCard.promotion.learnmore']}}
产品信息
14322-1-AP
种属反应
宿主/亚型
分类
类型
抗原
偶联物
形式
浓度
规格
纯化类型
保存液
内含物
保存条件
运输条件
产品详细信息
Immunogen sequence: MLPWTALGL ALSLRLALAR SGAERGPPAS APRGDLMFLL DSSASVSHYE FSRVREFVGQ LVAPLPLGTG ALRASLVHVG SRPYTEFPFG QHSSGEAAQD AVRASAQRMG DTHTGLALVY AKEQLFAEAS GARPGVPKVL VWVTDGGSSD PVGPPMQELK DLGVTVFIVS TGRGNFLELS AAASAPAEKH LHFVDVDDLH IIVQELRGSI LDAMRPQQLH ATEITSSGFR LAWPPLLTAD SGYYVLELVP SAQPGAARRQ QLPGNATDWI WAGLDPDTDY DVALVPESNV RLLRPQILRV RTRPGEAGPG ASGPESGAGP APTQLAALPA PEEAGPERIV ISHARPRSLR VSWAPALGSA AALGYHVQFG PLRGGEAQRV EVPAGRNCTT LQGLAPGTAY LVTVTAAFRS GRESALSAKA CTPDGPRPRP RPVPRAPTPG TASREP (1-445 aa encoded by B C059409)
靶标信息
VWA1 (also known as WARP) is a member of the von Willebrand factor A-domain (VA-domain) superfamily of extracellular matrix proteins which may play a role in cartilage structure and function. VWA1 is a multimeric component of the chondrocyte pericellular matrix in articular cartilage and intervertebral disc, where it interacts with the basement membrane heparan sulfate proteoglycan perlecan. VWA1 may have a role in maintaining the blood-brain barrier.
仅用于科研。不用于诊断过程。未经明确授权不得转售。
生物信息学
蛋白别名: unnamed protein product; von Willebrand factor A domain-containing protein 1; von Willebrand factor A domain-related protein
基因别名: HMNMYO; HMNR7; VWA1; WARP
UniProt ID: (Human) Q6PCB0
Entrez Gene ID: (Human) 64856